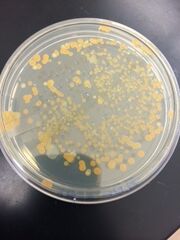
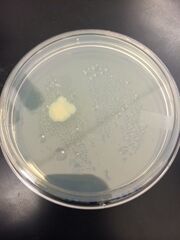

Uploads by Alexandra Schultz
From OpenWetWare
Jump to navigationJump to search
This special page shows all uploaded files.
| Date | Name | Thumbnail | Size | Description |
|---|---|---|---|---|
| 23:26, 6 March 2015 | Dead15th.JPG (file) |  |
20 KB | |
| 23:26, 6 March 2015 | Control15dead.JPG (file) |  |
18 KB | |
| 23:26, 6 March 2015 | Caffeine15dead.JPG (file) |  |
17 KB | |
| 19:50, 3 March 2015 | Controlday11.jpg (file) |  |
4 KB | |
| 19:49, 3 March 2015 | Mb38ok.png (file) |  |
94 KB | |
| 19:49, 3 March 2015 | Mb31ok.png (file) |  |
91 KB | |
| 23:53, 2 March 2015 | Caffday11.jpg (file) |  |
10 KB | |
| 01:52, 2 March 2015 | Controlday71.jpg (file) |  |
17 KB | |
| 01:52, 2 March 2015 | Controlday7.jpg (file) |  |
16 KB | |
| 01:52, 2 March 2015 | Caffeineday7.jpg (file) |  |
15 KB | |
| 01:49, 2 March 2015 | Pcrresult1.jpg (file) |  |
28 KB | |
| 20:16, 23 February 2015 | Table1embryo.jpg (file) |  |
34 KB | |
| 19:21, 23 February 2015 | Nocafmon.jpg (file) |  |
14 KB | |
| 19:21, 23 February 2015 | Nocaffri.jpg (file) |  |
15 KB | |
| 19:21, 23 February 2015 | Cafmon2.jpg (file) |  |
16 KB | |
| 19:21, 23 February 2015 | Cafmon1.jpg (file) |  |
14 KB | |
| 19:21, 23 February 2015 | Caffri.jpg (file) |  |
14 KB | |
| 17:40, 19 February 2015 | Diagram4vert.jpg (file) |  |
22 KB | |
| 04:20, 19 February 2015 | Claw.jpg (file) |  |
19 KB | |
| 04:17, 19 February 2015 | Worms1.jpg (file) |  |
35 KB | |
| 04:15, 19 February 2015 | Planaria1.jpg (file) |  |
21 KB | |
| 04:15, 19 February 2015 | Soilmites.jpg (file) |  |
43 KB | |
| 04:15, 19 February 2015 | Invertclaw.jpg (file) |  |
341 KB | |
| 04:15, 19 February 2015 | Tableofstuff.jpg (file) |  |
25 KB | |
| 04:15, 19 February 2015 | Nematodes1.jpg (file) |  |
24 KB | |
| 19:14, 12 February 2015 | Mush.jpg (file) |  |
23 KB | |
| 19:14, 12 February 2015 | Moldpic.jpg (file) |  |
20 KB | |
| 19:14, 12 February 2015 | Leafdata.jpg (file) |  |
34 KB | |
| 19:14, 12 February 2015 | Bf.jpg (file) |  |
40 KB | |
| 19:12, 12 February 2015 | Fiveleaf.jpg (file) |  |
20 KB | |
| 20:34, 5 February 2015 | Table2pro3.jpg (file) |  |
29 KB | |
| 20:34, 5 February 2015 | Pic4gram.jpg (file) |  |
31 KB | |
| 20:33, 5 February 2015 | Pic3gram.jpg (file) |  |
32 KB | |
| 20:33, 5 February 2015 | Pic2gram.jpg (file) |  |
25 KB | |
| 20:32, 5 February 2015 | Pic1gram.jpg (file) |  |
25 KB | |
| 20:32, 5 February 2015 | Movingone.jpg (file) |  |
19 KB | |
| 20:31, 5 February 2015 | 109tet.jpg (file) |  |
22 KB | |
| 20:31, 5 February 2015 | 107tet.jpg (file) |  |
24 KB | |
| 20:30, 5 February 2015 | 105tet.jpg (file) | |
31 KB | |
| 20:30, 5 February 2015 | 109nut.jpg (file) | |
25 KB | |
| 20:29, 5 February 2015 | 107nut.jpg (file) |  |
26 KB | |
| 20:29, 5 February 2015 | 105nut.jpg (file) |  |
30 KB | |
| 20:28, 5 February 2015 | Table4pro1.jpg (file) |  |
32 KB | |
| 20:27, 5 February 2015 | Allplatesok.jpg (file) |  |
30 KB | |
| 19:20, 29 January 2015 | Diagramplates.jpg (file) |  |
1.16 MB | |
| 19:20, 29 January 2015 | Paramm.jpg (file) |  |
551 KB | |
| 19:19, 29 January 2015 | Clammy.jpg (file) |  |
1.3 MB | |
| 19:18, 29 January 2015 | Euggy.jpg (file) |  |
644 KB | |
| 19:17, 29 January 2015 | PAur.jpg (file) |  |
827 KB | |
| 19:17, 29 January 2015 | EandPB.jpg (file) |  |
907 KB |